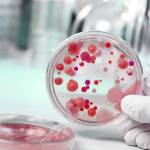

Молочница (или генитальный кандидоз) – очень распространенная проблема со здоровьем, от которой ежегодно страдают 130 миллионов женщин во всем мире. Для многих женщин это может быть источником дискомфорта и крайне неприятных ощущений, выделений, смущения и проблем в личной жизни. Хотя есть стандартные протоколы лечения инфекции, все больше людей ищут естественные способы борьбы с симптомами и предотвращения рецидивов инфекции. Пробиотики (полезные бактерии, которые принимаются с пищей или в добавках) стали популярным вариантом. Тем не менее, выбор правильного пробиотика для борьбы с молочницей очень важен, поскольку некоторые из них намного эффективнее других. Некоторые из наиболее хорошо изученных пробиотических штаммов, которые, как показали клинические испытания, помогают при молочнице, — это Lactobacillus reuteri (штамм RC-14) и Lactobacillus rhamnosus (штамм GR-1). Эти интересные штаммы подробно обсуждаются ниже.
Что такое молочница?
Кандидоз, кандидозный вагинит или молочница (все это синонимы) — это грибковая инфекция, вызываемая патогенными (вредными, опасными) дрожжами. Инфекция может возникнуть во рту (молочница во рту) или в области гениталий (вульвовагинальный кандидоз). Типичные симптомы вагинальной молочницы включают:
- достаточно обильные выделения из влагалища: они обычно кремово-белые, «творожные», обильные, обычно без запаха.
- зуд и раздражение интимной зоны, затрагивающие половые губы и вход во влагалище. В крайне редких, тяжелых случаях возможно нарушение целостности кожи и раздражение.
Другие возможные дополнительные симптомы — боль во время полового акта, дискомфорт либо жжение при мочеиспускании, иногда бессимптомное носительство.
Женщины часто могут страдать от множественных приступов молочницы, частота рецидивов довольно высока: во всем мире распространенность поражения составляет около 9% женщин в возрасте от 25 до 34 лет. Традиционное лечение включает использование местных противогрибковых кремов, противогрибковых пессариев или оральных противогрибковых таблеток. Однако их широкое использование отрицательно влияет на уже повышающийся уровень противогрибковой устойчивости Candida spp. И нередко повторное лечение этими же препаратами уже не эффективно.
Врачи отмечают, что пробиотики могут играть важную роль в лечении молочницы, особенно в качестве дополнения к основным терапевтическим методам. Специалисты подчеркивают, что определенные штаммы пробиотиков, такие как Lactobacillus rhamnosus и Lactobacillus reuteri, способны восстанавливать нормальную микрофлору влагалища и подавлять рост грибков рода Candida. Важно, чтобы пробиотики использовались под контролем врача, так как выбор конкретного препарата и его дозировка могут варьироваться в зависимости от индивидуальных особенностей пациента. Некоторые эксперты рекомендуют комбинированный подход, включающий пробиотики и противогрибковые средства, что может значительно повысить эффективность лечения. Однако окончательное решение о применении пробиотиков должно приниматься на основании клинической картины и результатов анализов.

Факторы риска развития молочницы
Кандидоз (либо он же молочница) обычно вызывается патогенными дрожжами, известными как Candida. Грибок естественным образом живет в организме – в кишечнике, во рту, на коже и во влагалище. В небольшом количестве они обычно считаются безвредными. Наиболее распространенным видом Candida, который может вызвать молочницу, является Candida albicans. Количество колоний грибка может увеличиваться на коже или слизистых при дисбалансе микробиома, известном как дисбактериоз.
Микробиом человека – это название, данное микробам, которые живут в человеческом теле или внутри него, включая бактерии и дрожжи. В совокупности они образуют экосистему. Обычно в нашем микробиоме существует тонкий баланс между полезными микробами и патогенными их вариантами. Симптомы молочницы могут развиться при чрезмерном росте C. albicans во рту или в области гениталий. Считается, что этот чрезмерный рост происходит в результате нарушения нашего микробиома, что приводит к дисбактериозу . Это нарушение может произойти из-за таких факторов, как:
- использование лекарств — антибиотики, оральные контрацептивы или заместительная гормональная терапия, кортикостероиды;
- колебания уровня гормонов, например, во время беременности;
- нарушение естественного баланса pH во влагалище, вызванное местными факторами, такими как использование ароматных интимных продуктов и мыла;
- основные заболевания, такие как сахарный диабет;
- Диетические привычки — чрезмерное употребление алкоголя, диеты с высоким содержанием сахара / низким содержанием клетчатки;
- сексуальная активность.
Микробиом влагалища уникален и отличается от микробиома полости рта и кишечника. В здоровом вагинальном микробиоме должны преобладать бактерии, лактобациллы. Лактобациллы могут оказывать множество защитных эффектов, обеспечивая здоровье влагалищного тракта и снижая риск инфекций. Когда их уровни истощаются, может возникать дисбаланс, и могут процветать условно-патогенные микроорганизмы, такие как C. albicans.
Могут ли пробиотики помочь при молочнице?
Да, пробиотики могут помочь справиться с молочницей. Клинические исследования показали, что оптимизация содержания полезных бактерий с помощью пробиотиков может помочь сохранить здоровый микробиом влагалища. Однако пробиотики работают по-разному — многие работают преимущественно в кишечнике. Не все лактобациллы попадают даже во влагалище. Важно найти штаммы пробиотиков, которые имеют доказательства вагинальной колонизации и прошли клинические испытания против молочницы.
Пробиотики становятся все более популярными в борьбе с молочницей, и мнения людей о них варьируются. Многие отмечают, что пробиотики помогают восстановить баланс микрофлоры, что особенно важно при лечении кандидоза. Пользователи часто делятся положительным опытом, утверждая, что регулярное употребление пробиотиков способствует уменьшению симптомов и предотвращает рецидивы.
Наиболее рекомендуемыми являются пробиотики, содержащие штаммы Lactobacillus, такие как Lactobacillus rhamnosus и Lactobacillus reuteri. Эти штаммы, по мнению многих, эффективно подавляют рост грибков и способствуют улучшению общего состояния. Однако важно помнить, что пробиотики не являются панацеей и должны использоваться в сочетании с основным лечением, назначенным врачом. Всегда стоит консультироваться с медицинским специалистом перед началом приема пробиотиков, чтобы выбрать наиболее подходящий вариант.

Какой пробиотик лучше всего при молочнице?
Ряд клинических испытаний, тестировавших комбинацию двух конкретных пробиотических штаммов, Lactobacillus reuteri RC-14 и Lactobacillus rhamnosus GR-1 оказались полезными для поддержания здоровья влагалища . Лучшие пробиотики от молочницы включают два штамма бактерий, L. reuteri RC-14 и L. rhamnosus GR-1, которые являются одними из наиболее исследованных пробиотиков на сегодняшний день и, безусловно, являются наиболее изученными с точки зрения женского интимного здоровья.
В рандомизированном контролируемом исследовании Martinez et al. 2009 г. 55 женщин с диагнозом кандидозный вульвовагинит были разделены на две группы: одна группа получала 2 миллиарда КОЕ Lactobacillus reuteri RC-14 и Lactobacillus rhamnosus GR-1, а другая группа получала плацебо в течение 4 недель. Обе группы первоначально получали 150 мг флуконазола перорально.
Было отмечено значительное уменьшение выделений из влагалища, что соответствовало уменьшению количества дрожжевых клеток в вагинальных мазках. Больше субъектов с рецидивирующей инфекцией дали положительный результат на Candida spp. на вагинальных мазках по сравнению с группой пробиотиков в конце 4 недель (80% и 18,2% соответственно).
Это показывает, что использование этих двух штаммов пробиотических бактерий вместе с обычными пероральными противогрибковыми препаратами может быть полезным при молочнице. В дальнейших исследованиях Anukam et al. в 2009 г. пероральный прием этих двух штаммов наряду с традиционным лечением привел к снижению рецидивов инфекций в будущем.
Помогает ли живой йогурт от молочницы?
Живые йогурты — хороший источник полезных бактерий. Полезно употреблять пробиотические продукты, такие как живой йогурт, для улучшения общего состояния здоровья. Поддержание здоровья кишечного микробиома за счет употребления в пищу живого йогурта, в свою очередь, поможет вагинальному микробиому избежать дисбаланса, который может привести к молочнице. Однако пробиотические бактерии, присутствующие в живом йогурте, не являются специфическими для здоровья влагалища и могут даже не достигать интимной зоны. Использование пробиотической добавки, которая была клинически исследована для поддержания здоровья влагалища, может обеспечить гораздо более целенаправленный подход при лечении молочницы.

Как добавки с пробиотиками помогают предотвратить молочницу?
Было показано, что Lactobacillus reuteri и Lactobacillus rhamnosus обладают противогрибковыми свойствами. Оба штамма могут вырабатывать молочную кислоту, что помогает снизить pH во влагалищном тракте (pH 4 или ниже). Эта кислотность создает неблагоприятную среду для C. albicans, тем самым ограничивая рост. Штаммы пробиотиков также могут прилипать к слизистой оболочке влагалища и создавать физический барьер, ограничивающий пространство и питательные вещества, доступные для C.albicans (известное как конкурентное ингибирование).
Кроме того, оба штамма могут уменьшить воспаление, связанное с инфекцией C. albicans. Эти штаммы подавляли рост Candida albicans за счет производства противогрибковой, молочной кислоты и конкурентного ингибирования, используя пространство и питательные вещества, необходимые для роста Candida albicans.
Снижение риска молочницы
При лечении кандидоза или снижении риска молочницы, возможно, потребуется учитывать другие факторы образа жизни. Попытайся избегать:
- облегающего белья и колготок;
- парфюмированного мыла и гелей для душа, включая продукты, специально предназначенные для влагалища;
- алкоголя и продуктов с высоким содержанием сахара.
Стоит выбирать:
- Пробиотик хорошего качества, специально разработанный для интимного здоровья женщин.
- Нижнее белье из хлопка, а не из синтетических материалов
- Для мытья интимной зоны пользоваться только водой или чистой влажной тканью.
Важно
Хотя женщины страдают молочницей влагалища, реже молочница может развиться и у мужчин.
Оральная молочница
Приведенная выше информация относится преимущественно к вагинальной молочнице. Необходимы дополнительные научные исследования, но предварительные исследования подтверждают теорию о том, что пробиотики могут играть определенную роль в лечении молочницы полости рта.
Парецкая Алена, врач, медицинский обозреватель
Вопрос-ответ
Какой пробиотик при молочнице?
Лактожиналь® – лекарственный препарат — пробиотик, имеющий прямое зарегистрированное показание — «профилактика рецидивов вульвовагинального кандидоза (включая обострения рецидивирующего ВВК) после местной и/или системной терапии противогрибковыми препаратами».
Какой пробиотик лучше всего подходит для лечения молочницы?
Некоторые из наиболее хорошо изученных пробиотических штаммов, которые, как показали клинические испытания, помогают при молочнице, — это Lactobacillus reuteri RC- 14® и Lactobacillus rhamnosus GR- 1® .
Какой пробиотик лучше всего подходит для лечения кандидоза?
Вагинальный молочница может быть еще одним неприятным и постоянным проявлением инфекции Candida для многих женщин. Два штамма пробиотиков имеют более чем 30-летние научные доказательства в поддержку их использования при этом состоянии – Lactobacillus rhamnosus GR-1 ® и Lactobacillus reuteri RC-14 ® .
Могут ли пробиотики вылечить молочницу?
Да, пробиотики могут помочь в лечении молочницы и дрожжевых инфекций .
Советы
СОВЕТ №1
Перед началом приема пробиотиков обязательно проконсультируйтесь с врачом. Специалист поможет определить, какие именно пробиотики подойдут для вашего случая, и исключит возможные противопоказания.
СОВЕТ №2
Выбирайте пробиотики с разнообразными штаммами бактерий. Исследования показывают, что комбинация различных пробиотических штаммов может быть более эффективной в борьбе с молочницей, чем использование одного штамма.
СОВЕТ №3
Обратите внимание на форму выпуска пробиотиков. Некоторые из них могут быть более эффективными в виде капсул или порошков, в то время как другие лучше усваиваются в виде йогуртов или ферментированных продуктов. Выбирайте тот вариант, который вам удобнее.
СОВЕТ №4
Дополняйте прием пробиотиков сбалансированной диетой, богатой клетчаткой и низким содержанием сахара. Это поможет создать оптимальные условия для роста полезных бактерий и поддержит здоровье микрофлоры.